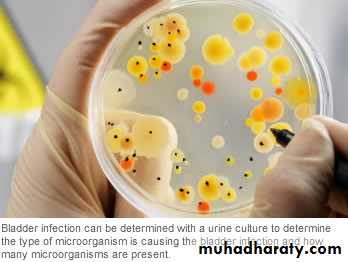

BLADDER CANCER
URO ONCOLOGYDONE BY:
SHATHA MUQBILSHAMS KADHIM
The bladder is an extraperitoneal muscular urine reservoir that lies behind the pubis symphysis in the pelvis .
The ureters, which transport urine from kidney to bladder, approach the bladder obliquely and posterosuperiorly, entering at the trigone (the area between the interureteric ridge and the bladder neck). The bladder neck serves as an internal sphincter.
In males, the seminal vesicles, vas deferens, ureters, and rectum border the inferoposterior aspect of the bladder. Anteriorly there is space filled with fibroadipose tissue and the prevesical fascia. The dome and posterior surface of the bladder are covered by parietal peritoneum, which reflects superiorly to the seminal vesicles and is continuous with the anterior rectal peritoneum.
In females, the posterior peritoneal reflection is continuous with the uterus and vagina.
ANATOMY:ANATOMY:
Almost all bladder cancers originate in the urothelium, which is a 3- to 7-cell mucosal layer within the muscular bladder. Squamous cell carcinoma of the bladder can involve multiple sites; however, the lateral wall and trigone are more commonly involved. 90% of bladder cancers are TCC. In developing countries—particularly in the Middle East and Africa—the majority are SCCs, and most of these are secondary to Schistosoma haematobium infection
BLADDER CANCER:
BLADDER CANCER:
Causes:Tobacco smoking is the main known contributor; & associated with over half of cases in men and one-third among women.
occupational exposure in the workplace to carcinogens such as benzidine & naphthylamine, Occupations at risk are bus drivers, rubber workers, motor mechanics, leather (including shoe) workers, machine setters, and mechanics. Hairdressers are thought to be at risk as well because of their frequent exposure to permanent hair dyes.
It has been suggested that mutations at HRAS, KRAS2, RB1, and FGFR3 may be associated in some cases.
The incidence of bladder cancer increases with age, with the median age at diagnosis being 65 years; & rarely diagnosed before age 40 years.
Bladder cancer is about 3 times more common in men than in women.
The incidence of bladder cancer is twice as high in white men as in black men in the United States. However, blacks have a worse prognosis than whites.
CLINICAL PRESENTATION:
BY HISTORY:painless gross hematuria (80-90%)
MALAGNANCY UNTIL PROVED OTHERWISED
Irritative bladder symptoms :
dysuria, urgency, or frequency of urination (20-30%)
may be related to more advanced muscle-invasive disease, carcinoma in situ (CIS) is the more likely cause
pelvic or bony pain, lower-extremity edema from iliac vessel compression, or flank pain from ureteral obstruction
THIS INDICATE A MORE ADVANCED DISEASE
BY EXAMINATION:
typically nothing significant during a physical examination. In rare cases, a mass is palpable during abdominal, pelvic, rectal, or bimanual examination. A bimanual examination may be considered part of the staging of such lesions
Attention to the anterior vaginal wall in women and the prostate in men may reveal findings that suggest local extension of bladder cancer. Assessment of fixation of the bladder to the surrounding pelvic sidewall is also important when planning definitive management for locally advanced tumors that may not be surgically resectable.
Approach Considerations
Urine studies include the following:Urinalysis with microscopy to detect hematuria or infection
Urine culture to rule out infection, if suspected
Voided urinary cytology: is extremely valuable and is often the test used for diagnosis.
IT is most helpful in diagnosing high-grade tumors and carcinoma in situ (CIS). Low-grade, noninvasive tumors may be missed by routine cytologic analysis
.
Urinary tumor marker testing may help in the early detection and prediction of urothelial carcinoma. however, no urinary assay has been shown to effectively replace urine cytology and cystoscopy.
DIAGNOSIS:
DIAGNOSIS:
Imiging:Computed tomography (CT) scans of the abdomen and pelvis with contrast are recommended.
magnetic resonance imaging (MRI) and renal ultrasonography.
Few US centers still perform intravenous pyelography (IVP) for upper tract imaging.
The bladder urothelium is not well visualized with routine imaging studies, including CT scanning and MRI. Small tumors are easily missed on images produced by these modalities. Irregular areas on images, which may appear to represent mucosal abnormalities, are often artifacts of incomplete bladder filling; delayed images following contrast administration can better visualize actual filling defects. CIS is not visible on images from any current radiographic study
Cystoscopy:
Is gold standard for detecting bladder cancer, but it is invasive and relatively expensive. Moreover, visibility can be reduced by bleeding, and flat urothelial lesions such as CIS may be difficult to distinguish from normal bladder tissue. Use of adjunctive endoscopic techniques may improve the accuracy of cystoscopy.DIAGNOSIS:
DIAGNOSIS:
DIAGNOSIS:
TNM Classification CT & MRITis Complete TURT + Intravesical BCG
Ta (Single) Complete TURTTa (Multiple) Complete TURT + Intraveiscal chemotherapy
T1 Complete TURT + Intravesical Chemotherapy
T2 – T4 1) Radical Cystectomy 2) Neoadjuvant Chemotherapy + Radical Cystectomy 3) Radical Cystectomy + Adjuvant Chemotherapy
Any T , N+ , M+ Systemic Chemotherapy followed by selective surgery
TREATMENT:
according to StageTREATMENT:
Intra-Vesical ChemoInstilled directly into the Bladder via a Urinary Catheter to avoid morbidity of systemic administration.
• Adjunctive : at time of TURT to prevent implantation
• Prophylactic : after complete TURT to delay recurrence or progression
• Therapeutic : after Incomplete TURT to cure residual tumor.
To improve efficacy :
• Avoid Air instillation• Increase contact time
• Increase drug conc. By decreasing fluid intake
• Changing patient’s position during therapy
BCGMitomycin-CThiotepa
Is the initial treatment for most bladder cancers .
Patient should be checked every 3 months after the operation for recurrence.
TREATMENT:
TURTTREATMENT:
Radical CystectomyThe Gold Standard for Muscle-Invasive CA.
Includes removal of :In Male : Bladder ( &its surrounding fat and peritoneal attachment) Prostate Seminal Vesicles
In Female : Bladder ( &its surrounding fat and peritoneal attachment ) Ovaries Uterus Cervix Anterior Vaginal Vault.